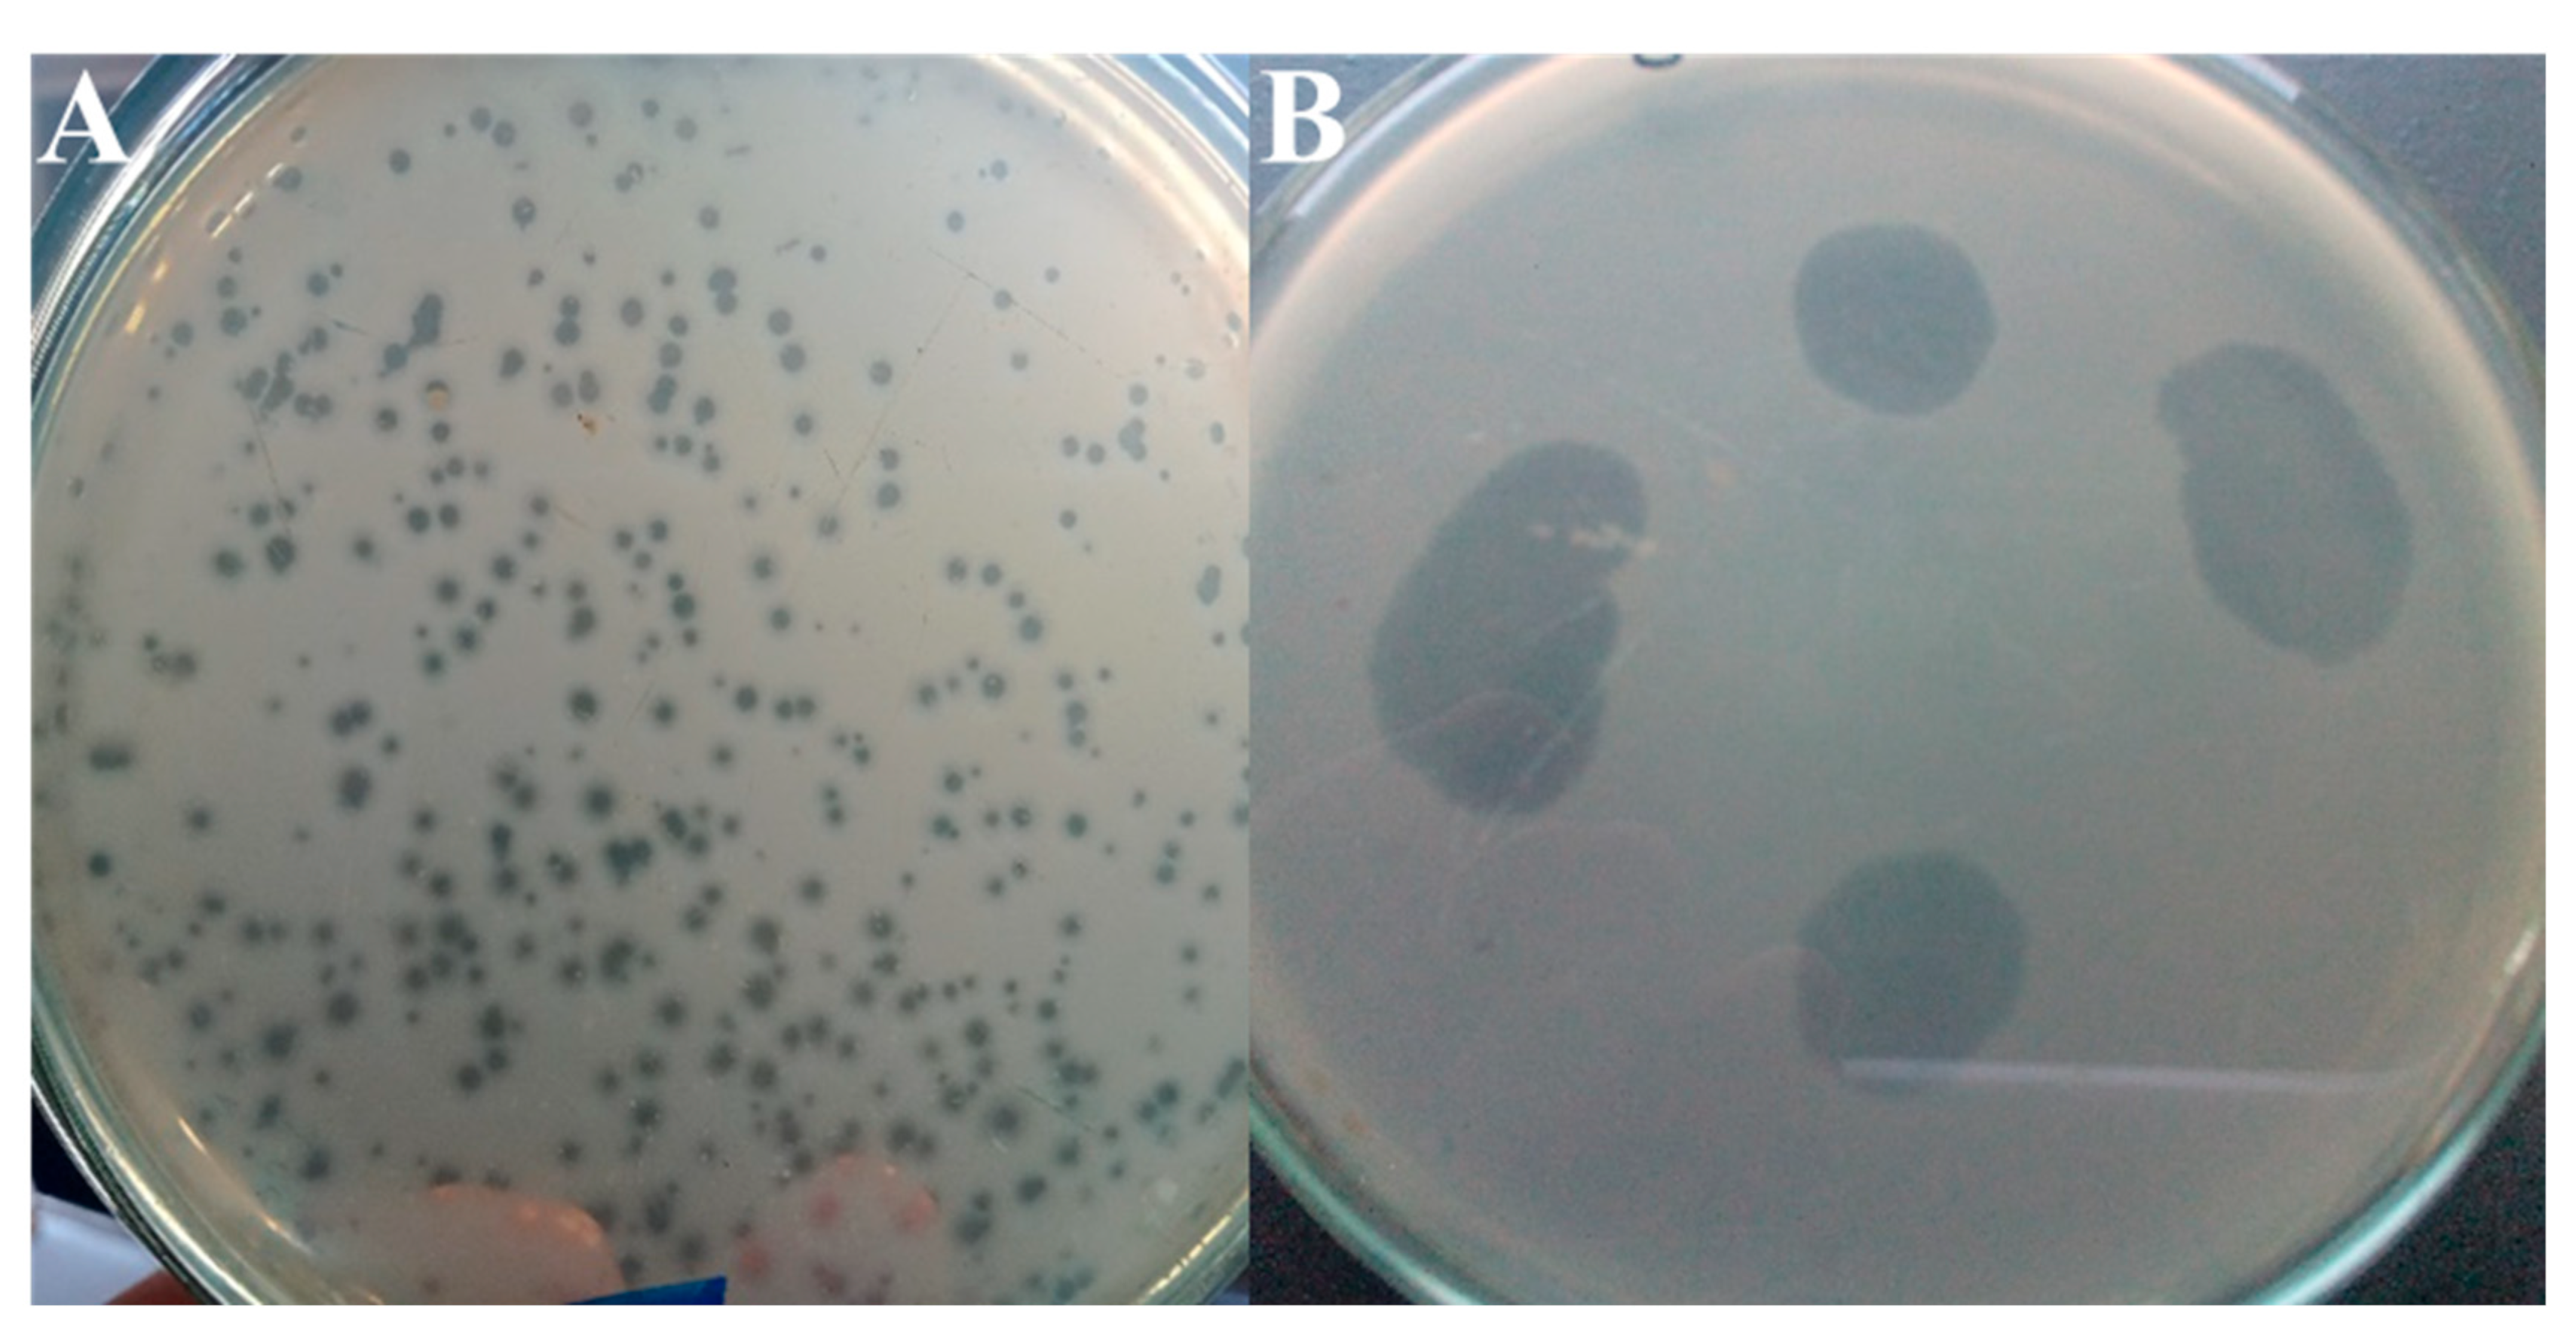
Horticulturae 11 00257 g001 Horticulturae 11 00257 g001

Carrier-Based Application of RsPod1EGY Phage to Effective Control Potato Bacterial Wilt
Abstract
1. Introduction
2. Materials and Methods
2.1. Soil Samples
2.2. Soil Chemical Analysis
2.3. Potato Tubers
2.4. Bacterial Strains and Growth Conditions
2.5. The Phage RsPod1EGY Used in This Study
2.6. RsPod1EGY Phage Survival in Different Carrier Types
2.7. Evaluation of Phage Activity in Various Carrier Types in a Greenhouse Potato Pot Experiment
2.8. Disease Assessments
2.9. Potato Yield Calculation
2.10. Statistical Analysis
3. Results
3.1. Soil Chemical Properties
3.2. Lytic Activity of RsPod1EGY Phage Against R. solanacearum
3.3. Survival of RsPod1EGY Phage in Different Carrier Types
3.4. Assessment of the Phage Activity Using Different Carrier Types Under Greenhouse Conditions
3.5. Effect of Soil Amendments and Phage Application on Pathogen Population, and Phage Survival
3.6. Impact of Phage and Soil Amendments on Potato Yield
4. Discussion
5. Conclusions
Author Contributions
Funding
Data Availability Statement
Conflicts of Interest
References
- El-Nagar, A.S.; Abdel Wahab, M.H.; Elzaawely, A.A.; El-Zahaby, H.M. Morphological and Molecular Identification of Fusarium incarnatum as the Causal Agent of Potato Dry Rot Disease. J. Sustain. Agric. Environ. Sci. 2024, 3, 68–73. [Google Scholar] [CrossRef]
- FAOSTAT FAO. Agriculture Organization of the United Nations FAO Statistical Database; FAO: Faro, Portugal, 2023. [Google Scholar]
- Ramesh, R.; Achari, G.A.; Gaitonde, S. Genetic Diversity of Ralstonia solanacearum Infecting Solanaceous Vegetables from India Reveals the Existence of Unknown or Newer Sequevars of Phylotype I Strains. Eur. J. Plant Pathol. 2014, 140, 543–562. [Google Scholar] [CrossRef]
- Elazouni, I.; Abdel-Aziz, S.; Rabea, A. Microbial Efficacy as Biological Agents for Potato Enrichment as Well as Bio-Controls against Wilt Disease Caused by Ralstonia solanacearum. World J. Microbiol. Biotechnol. 2019, 35, 30. [Google Scholar] [CrossRef] [PubMed]
- Álvarez, B.; Biosca, E.G.; López, M.M. On the Life of Ralstonia solanacearum, a Destructive Bacterial Plant Pathogen. Curr. Res. Technol. Educ. Top. Appl. Microbiol. Microb. Biotechnol. 2010, 1, 267–279. [Google Scholar]
- Safni, I.; Cleenwerck, I.; De Vos, P.; Fegan, M.; Sly, L.; Kappler, U. Polyphasic taxonomic revision of the Ralstonia solanacearum species complex: Proposal to emend the descriptions of Ralstonia solanacearum and Ralstonia syzygii and reclassify current R. syzygii strains as Ralstonia syzygii subsp. syzygii subsp. nov., R. solanacearum phylotype IV strains as Ralstonia syzygii subsp. indonesiensis subsp. nov., banana blood disease bacterium strains as Ralstonia syzygii subsp. celebesensis subsp. nov. and R. solanacearum phylotype I and III strains as Ralstonia pseudosolanacearum sp. nov. Int. J. Syst. Evol. Microbiol. 2014, 64, 3087–3103. [Google Scholar]
- Ingel, B.; Caldwell, D.; Duong, F.; Parkinson, D.Y.; McCulloh, K.A.; Iyer-Pascuzzi, A.S.; McElrone, A.J.; Lowe-Power, T.M. Revisiting the Source of Wilt Symptoms: X-Ray Microcomputed Tomography Provides Direct Evidence That Ralstonia Biomass Clogs Xylem Vessels. PhytoFrontiers 2022, 2, 41–51. [Google Scholar] [CrossRef]
- Buttimer, C.; McAuliffe, O.; Ross, R.P.; Hill, C.; OMahony, J.; Coffey, A. Bacteriophages and Bacterial Plant Diseases. Front. Microbiol. 2017, 8, 34. [Google Scholar] [CrossRef]
- Bae, J.Y.; Wu, J.; Lee, H.J.; Jo, E.J.; Murugaiyan, S.; Chung, E.; Lee, S.-W. Biocontrol Potential of a Lytic Bacteriophage PE204 against Bacterial Wilt of Tomato. J. Microbiol. Biotechnol. 2012, 22, 1613–1620. [Google Scholar] [CrossRef]
- Yu, T.; Mahe, L.; Li, Y.; Wei, X.; Deng, X.; Zhang, D. Benefits of Crop Rotation on Climate Resilience and Its Prospects in China. Agronomy 2022, 12, 436. [Google Scholar] [CrossRef]
- Schreinemachers, P.; Tipraqsa, P. Agricultural Pesticides and Land Use Intensification in High, Middle and Low Income Countries. Food Policy 2012, 37, 616–626. [Google Scholar] [CrossRef]
- Wei, C.; Liu, J.; Maina, A.N.; Mwaura, F.B.; Yu, J.; Yan, C.; Zhang, R.; Wei, H. Developing a Bacteriophage Cocktail for Biocontrol of Potato Bacterial Wilt. Virol. Sin. 2017, 32, 476–484. [Google Scholar] [CrossRef]
- Mamphogoro, T.P.; Babalola, O.O.; Aiyegoro, O.A. Sustainable Management Strategies for Bacterial Wilt of Sweet Peppers (Capsicum annuum) and Other Solanaceous Crops. J. Appl. Microbiol. 2020, 129, 496–508. [Google Scholar] [CrossRef] [PubMed]
- Garvey, M. Bacteriophages and Food Production: Biocontrol and Bio-Preservation Options for Food Safety. Antibiotics 2022, 11, 1324. [Google Scholar] [CrossRef] [PubMed]
- Umrao, P.D.; Kumar, V.; Kaistha, S.D. Biocontrol Potential of Bacteriophage Sp1 against Bacterial Wilt-Causing Ralstonia solanacearum in Solanaceae Crops. Egypt. J. Biol. Pest Control 2021, 31, 1–12. [Google Scholar] [CrossRef]
- Elhalag, K.; Nasr-Eldin, M.; Hussien, A.; Ahmad, A. Potential Use of Soilborne Lytic Podoviridae Phage as a Biocontrol Agent against Ralstonia solanacearum. J. Basic Microbiol. 2018, 58, 658–669. [Google Scholar] [CrossRef] [PubMed]
- Elhalag, K.; Elsaed, S.; Maswada, H.; Elzaawely, A. Effect of RsPod1EGY Phage on Ralstonia solanacearum In vitro. J. Sustain. Agric. Environ. Sci. 2024, 3, 75–81. [Google Scholar]
- Pastrik, K.-H.; Elphinstone, J.G.; Pukall, R. Sequence Analysis and Detection of Ralstonia solanacearum by Multiplex PCR Amplification of 16S–23S Ribosomal Intergenic Spacer Region with Internal Positive Control. Eur. J. Plant Pathol. 2002, 108, 831–842. [Google Scholar] [CrossRef]
- Elhalag, K.M.; Al-Anany, M.S.; Megahed, A.A. Efficacy of Plant Extracts and Bio-Fertilizers for the Control of Bacterial Wilt and Soft Rot Agents in Potato. J. Plant Pathol. 2025, 7, 1–21. [Google Scholar] [CrossRef]
- Askora, A.; Kawasaki, T.; Fujie, M.; Yamada, T. Lysogenic Conversion of the Phytopathogen Ralstonia solanacearum by the P2virus φRSY1. Front. Microbiol. 2017, 8, 2212. [Google Scholar] [CrossRef] [PubMed]
- Mihara, T.; Nasr-Eldin, M.A.; Chatchawankanphanich, O.; Bhunchoth, A.; Phironrit, N.; Kawasaki, T.; Nakano, M.; Fujie, M.; Ogata, H.; Yamada, T. A Ralstonia solanacearum Phage ϕRP15 Is Closely Related to Viunalikeviruses and Encodes 19 tRNA-Related Sequences. Virol. Rep. 2016, 6, 61–73. [Google Scholar] [CrossRef][Green Version]
- Messiha, N.A.S.; van Bruggen, A.H.C.; van Diepeningen, A.D.; de Vos, O.J.; Termorshuizen, A.J.; Tjou-Tam-Sin, N.N.A.; Janse, J.D. Potato Brown Rot Incidence and Severity under Different Management and Amendment Regimes in Different Soil Types. Eur. J. Plant Pathol. 2007, 119, 367–381. [Google Scholar] [CrossRef]
- Khairy, A.M.; Tohamy, M.R.A.; Zayed, M.A.; Ali, M.A.S. Detecting Pathogenic Bacterial Wilt Disease of Potato Using Biochemical Markers and Evaluate Resistant in Some Cultivars. Saudi J. Biol. Sci. 2021, 28, 5193–5203. [Google Scholar] [CrossRef]
- Elhalag, K.M.; Emara, H.M.; Messiha, N.A.S.; Elhadad, S.A.; Abdallah, S.A. The Relation of Different Crop Roots Exudates to the Survival and Suppressive Effect of Stenotrophomonas Maltophilia (PD 4560), Biocontrol Agent of Bacterial Wilt of Potato. J. Phytopathol. 2015, 163, 829–840. [Google Scholar] [CrossRef]
- Alomari, M.M.M.; Dec, M.; Urban-Chmiel, R. Bacteriophages as an Alternative Method for Control of Zoonotic and Foodborne Pathogens. Viruses 2021, 13, 2348. [Google Scholar] [CrossRef]
- Iriarte, F.B.; Balogh, B.; Momol, M.T.; Smith, L.M.; Wilson, M.; Jones, J.B. Factors Affecting Survival of Bacteriophage on Tomato Leaf Surfaces. Appl. Environ. Microbiol. 2007, 73, 1704–1711. [Google Scholar] [CrossRef]
- Vettori; Stotzky; Yoder; Gallori. Interaction between Bacteriophage PBS1 and Clay Minerals and Transduction of Bacillus Subtilis by Clay–Phage Complexes. Environ. Microbiol. 1999, 1, 347–355. [Google Scholar] [CrossRef] [PubMed]
- Fusi, P.; Ristori, G.G.; Calamai, L.; Stotzky, G. Adsorption and Binding of Protein on clean (Homoionic) and dirty(Coated with Fe Oxyhydroxides) Montmorillonite, Illite and Kaolinite. Soil Biol. Biochem. 1989, 21, 911–920. [Google Scholar] [CrossRef]
- Chu, Y.; Jin, Y.; Baumann, T.; Yates, M.V. Effect of Soil Properties on Saturated and Unsaturated Virus Transport through Columns. J. Environ. Qual. 2003, 32, 2017–2025. [Google Scholar] [CrossRef] [PubMed]
- Kalpage, M.D.; De Costa, D.M. Isolation of Bacteriophages and Determination of Their Efficiency in Controlling Ralstonia solanacearum Causing Bacterial Wilt of Tomato. Trop. Agric. Res. 2015, 26, 140–151. [Google Scholar] [CrossRef]
- Wang, N.; Wang, L.; Zhu, K.; Hou, S.; Chen, L.; Mi, D.; Gui, Y.; Qi, Y.; Jiang, C.; Guo, J.-H. Plant Root Exudates Are Involved in Bacillus cereus AR156 Mediated Biocontrol against Ralstonia solanacearum. Front. Microbiol. 2019, 10, 98. [Google Scholar] [CrossRef]
- Enebe, M.C.; Babalola, O.O. Soil Fertilization Affects the Abundance and Distribution of Carbon and Nitrogen Cycling Genes in the Maize Rhizosphere. AMB Express 2021, 11, 24. [Google Scholar] [CrossRef] [PubMed]
- Chen, L.; Xun, W.; Sun, L.; Zhang, N.; Shen, Q.; Zhang, R. Effect of Different Long-Term Fertilization Regimes on the Viral Community in an Agricultural Soil of Southern China. Eur. J. Soil Biol. 2014, 62, 121–126. [Google Scholar] [CrossRef]
- Gao, H.; Guo, M.; Song, J.; Ma, Y.; Xu, Z. Signals in Systemic Acquired Resistance of Plants against Microbial Pathogens. Mol. Biol. Rep. 2021, 48, 3747–3759. [Google Scholar] [CrossRef]
- Askora, A.; Kawasaki, T.; Fujie, M.; Yamada, T. Insights into the Diversity of varphiRSM Phages Infecting Strains of the Phytopathogen Ralstonia solanacearum Complex: Regulation and Evolution. Mol. Genet. Genom. 2014, 289, 589–598. [Google Scholar] [CrossRef]
- Balogh, B.; Jones, J.B.; Momol, M.T.; Olson, S.M.; Obradovic, A.; King, P.; Jackson, L.E. Improved Efficacy of Newly Formulated Bacteriophages for Management of Bacterial Spot on Tomato. Plant Dis. 2003, 87, 949–954. [Google Scholar] [CrossRef] [PubMed]
- Enebe, M.C.; Erasmus, M. Disease Suppression in Plants: A Perspective on the Impact of Phage-Directed Soil Fertilization in Enhancing Soil Health and Sustainability. Biol. Control 2024, 188, 105429. [Google Scholar] [CrossRef]
- Kumar, S.; Thakur, M.; Rani, A. Trichoderma: Mass Production, Formulation, Quality Control, Delivery and Its Scope in Commercialization in India for the Management of Plant Diseases. Afr. J. Agric. Res. 2014, 9, 3838–3852. [Google Scholar]
- Czajkowski, R.; Smolarska, A.; Ozymko, Z. The Viability of Lytic Bacteriophage ΦD5 in Potato-Associated Environments and Its Effect on Dickeya Solani in Potato (Solanum tuberosum L.) Plants. PLoS ONE 2017, 12, e0183200. [Google Scholar] [CrossRef] [PubMed]
- Fujiwara, A.; Fujisawa, M.; Hamasaki, R.; Kawasaki, T.; Fujie, M.; Yamada, T. Biocontrol of Ralstonia solanacearum by Treatment with Lytic Bacteriophages. Appl. Environ. Microbiol. 2011, 77, 4155–4162. [Google Scholar] [CrossRef]
- Nakkeeran, S.; Fernando, W.G.D.; Siddiqui, Z.A. Plant Growth Promoting Rhizobacteria Formulations and Its Scope in Commercialization for the Management of Pests and Diseases. In PGPR: Biocontrol and Biofertilization; Springer: Dordrecht, The Netherlands, 2006; pp. 257–296. [Google Scholar]
- Meena, B.; Radhajeyalakshmi, R.; Marimuthu, T.; Vidhyasekaran, P.; Velazhahan, R. Biological Control of Groundnut Late Leaf Spot and Rust by Seed and Foliar Applications of a Powder Formulation of Pseudomonas Fluorescens. Biocontrol Sci. Technol. 2002, 12, 195–204. [Google Scholar] [CrossRef]
- Nandakumar, R.; Babu, S.; Viswanathan, R.; Sheela, J.; Raguchander, T.; Samiyappan, R. A New Bio-Formulation Containing Plant Growth Promoting Rhizobacterial Mixture for the Management of Sheath Blight and Enhanced Grain Yield in Rice. Biocontrol 2001, 46, 493–510. [Google Scholar] [CrossRef]
- Sundaramoorthy, S.; Balabaskar, P. Consortial Effect of Endophytic and Plant Growth Promoting Rhizobacteria for the Management of Early Blight of Tomato Incited by Alternaria Solani. J. Plant. Pathol. Microbiol. 2012, 3, 1000145. [Google Scholar] [CrossRef]
- Zaczek-Moczydłowska, M.A.; Young, G.K.; Trudgett, J.; Plahe, C.; Fleming, C.C.; Campbell, K.; OHanlon, R. Phage Cocktail Containing Podoviridae and Myoviridae Bacteriophages Inhibits the Growth of Pectobacterium spp. under in Vitro and in Vivo Conditions. PLoS ONE 2020, 15, e0230842. [Google Scholar] [CrossRef] [PubMed]
- Bhunchoth, A.; Phironrit, N.; Leksomboon, C.; Chatchawankanphanich, O.; Kotera, S.; Narulita, E.; Kawasaki, T.; Fujie, M.; Yamada, T. Isolation of Ralstonia solanacearum-Infecting Bacteriophages from Tomato Fields in Chiang Mai, Thailand, and Their Experimental Use as Biocontrol Agents. J. Appl. Microbiol. 2015, 118, 1023–1033. [Google Scholar] [CrossRef] [PubMed]
- Wang, X.; Wei, Z.; Yang, K.; Wang, J.; Jousset, A.; Xu, Y.; Shen, Q.; Friman, V.-P. Phage Combination Therapies for Bacterial Wilt Disease in Tomato. Nat. Biotechnol. 2019, 37, 1513–1520. [Google Scholar] [CrossRef] [PubMed]

| Carrier Type | pH | EC | SP | Anions (meq/L) | Cations (meq/L) | Available Micro- and Macro- Elements in Soil Sample (mg/Kg Soil) | ||||||||||||
|---|---|---|---|---|---|---|---|---|---|---|---|---|---|---|---|---|---|---|
| CO3= | HCO3− | Cl− | SO4= | Ca++ | Mg++ | Na+ | K+ | N | K | P | Cu | Fe | Mn | Zn | ||||
| Compost | - | - | - | - | - | - | - | 2.7 | 0.81 | - | - | - | - | - | 76.3 | 1.5 | 521 | 114 |
| Peat moss | - | - | - | - | - | - | - | 1.43 | 0.33 | - | - | - | - | - | 73.0 | 0.25 | 345 | 114 |
| Sand | 7.32 | 0.9 | 18.5 | - | 0.6 | 7.4 | 0.99 | 1.9 | 2.5 | 4.34 | 0.15 | 29.9 | 83.22 | 31.64 | 0.94 | 6.34 | 0.92 | 1.39 |
| Clay | 7.2 | 1.39 | 40.5 | - | 1.5 | 10.5 | 1.59 | 2.5 | 3.65 | 7.32 | 0.24 | 33.1 | 232.4 | 1.57 | 3.52 | 14.1 | 2.3 | 1.28 |
| Treatment | Time from Soil Amendment (Days) | Mean ± SD | |||||||
|---|---|---|---|---|---|---|---|---|---|
| 0 | 3 | 5 | 10 | 14 | 21 | 30 | 60 | ||
| Compost | 7.91 ± 0.02 a | 7.86 ± 0.01 a | 7.83 ± 0.02 a | 7.77 ± 0.01 a | 7.76 ± 0.01 a | 6.69 ± 0.02 b | 5.61 ± 0.01 de | 4.12 ± 0.04 gh | 6.95 ± 1.39 a |
| Talc powder | 7.92 ± 0.01 a | 7.86 ± 0.02 a | 7.81 ± 0.01 a | 7.77 ± 0.01 a | 7.75 ± 0.02 a | 6.71 ± 0.02 b | 5.62 ± 0.01 de | 4.12 ± 0.06 gh | 6.95 ± 1.41 a |
| Peat moss | 7.91 ± 0.01 a | 7.85 ± 0.01 a | 7.54 ± 0.05 a | 6.32 ± 0.05 bc | 6.10 ± 0.09 bcd | 4.00 ± 0.07 gh | 1.53 ± 0.56 k | 0.00 ± 0.00 l | 5.15 ± 3.00 c |
| Clay soil | 7.92 ± 0.01 a | 7.85 ± 0.003 a | 6.07 ± 0.05 bcd | 4.87 ± 0.11 f | 3.27 ± 0.03 i | 2.58 ± 0.02 j | 0.00 ± 0.00 l | 0.00 ± 0.00 l | 4.07 ± 3.16 d |
| Wheat bran | 7.87 ± 0.03 a | 7.82 ± 0.03 a | 7.76 ± 0.002 a | 7.72 ± 0.006 a | 7.44 ± 0.04 a | 5.66 ± 0.02 cde | 4.55 ± 0.02 fg | 0.57 ± 0.08 l | 6.17 ± 2.57 b |
| Sandy soil | 7.87 ± 0.01 a | 6.34 ± 0.01 bc | 5.03 ± 0.08 ef | 3.68 ± 0.07 hi | 1.64 ± 0.77 k | 0.43 ± 0.39 l | 0.00 ± 0.00 l | 0.00 ± 0.00 l | 3.12 ± 3.07 e |
| Time point (Mean ± SD) | 7.90 ± 0.02 a | 7.60 ± 0.61 b | 7.01 ± 1.19 c | 6.36 ± 1.75 d | 5.66 ± 2.56 e | 4.34 ± 2.55 f | 2.88 ± 2.68 g | 1.45 ± 2.07 h | |
| PTreatment | <0.0001 | ||||||||
| Ptime | <0.0001 | ||||||||
| PTreatment x time | <0.0001 | ||||||||
| Treatment | Disease Severity% | DS Reduction (%) | AUDPC |
|---|---|---|---|
| C + RS C + RS + Ph | 100 ± 0.02 a 10 ± 0.22 d | -- 90 | 1357.36 ± 40.04 a 55.00 ± 12.90 d |
| PM + RS PM + RS + Ph | 100± 0.16 a 35 ± 0.50 b | -- 65 | 1328.87 ± 65.530 a 154.25 ± 17.80 bc |
| WB + RS WB + RS + Ph | 100± 0.24 a 15 ± 0.28 c | -- 85 | 1374.88 ± 69.70 a 58.00 ± 9.120 cd |
| TP + RS TP + RS + Ph | 100 ± 0.03 a 10 ± 0.02 d | -- 90 | 1335.27 ± 31.13 a 69.75 ± 10.34 cd |
| Ph | 35± 0.04 b | 65 | 177.0 ± 27.72 b |
| NC | 0.0 ± 0.0 e | -- | 0.00 ± 0.00 d |
| PC | 100 ± 0.06 a | -- | 1392.00 ± 39.00 a |
| p < 0.0001 | -- | p < 0.0001 |
| Treatment | LOG10 CFU RS in Soil (T0) | LOG10 CFU RS in Rhiz (T = 20) | LOG10 CFU RS in Rhiz (T = 40) | PCR for RS in Root (T = 80) |
|---|---|---|---|---|
| C + RS | 7.81 ± 0.48 a | 6.79 ± 0.33 b | 6.61 ± 0.13 a | + |
| C + RS + Ph | 7.85 ± 0.13 a | 4.49 ± 0.30 d | 1.93 ± 0.31 c | - |
| PM + RS | 7.84 ± 0.15 a | 6.71 ± 0.28 b | 6.56 ± 0.29 a | + |
| PM + RS + Ph | 7.87 ± 0.24 a | 4.48 ± 0.42 d | 3.04 ± 0.23 b | + |
| WB + RS | 7.83 ± 0.02 a | 7.75 ± 0.27 a | 6.81 ± 0.48 a | + |
| WB + RS + Ph | 7.81 ± 0.26 a | 4.52 ± 0.12 d | 2.86 ± 0.11 b | - |
| TP + RS | 7.83 ± 0.02 a | 7.84 ± 0.12 a | 6.77 ± 0.16 a | + |
| TP + RS + Ph | 7.82 ± 0.08 a | 4.42 ± 0.09 d | 1.13 ± 0.42 d | - |
| Ph | 7.86 ± 0.62 a | 5.30 ± 0.05 c | 3.45 ± 0.04 b | + |
| NC | 0.00 ± 0.00 b | 0.00 ± 0.00 e | 0.00 ± 0.00 e | - |
| PC | 7.81 ± 0.01 a | 7.87 ± 0.01 a | 6.85 ± 0.14 a | + |
| p < 0.0001 | p < 0.0001 | p < 0.0001 |
| Treatment | LOG10 PFU Phage in Soil (T = 0) | LOG10 PFU Phage in Rhizo (T = 20) | LOG10 PFU Phage in Rhizo (T = 40) |
|---|---|---|---|
| C + RS | 0.00 ± 0.00 b | 0.00 ± 0.00 b | 0.00 ± 0.00 f |
| C + RS + Ph | 7.81 ± 0.17 a | 6.83 ± 0.49 a | 4.33 ± 0.29 b |
| PM + RS | 0.00 ± 0.00 b | 0.00 ± 0.00 b | 0.00 ± 0.00 f |
| PM + RS + Ph | 7.83 ± 0.22 a | 6.73 ± 0.31 a | 1.76 ± 0.38 d |
| WB + RS | 0.00 ± 0.00 b | 0.00 ± 0.00 b | 0.00 ± 0.00 f |
| WB + RS + Ph | 7.80 ± 0.29 a | 6.81 ± 0.65 a | 3.35 ± 0.13 c |
| TP + RS | 0.00 ± 0.00 b | 0.00 ± 0.00 b | 0.00 ± 0.00 f |
| TP + RS + Ph | 7.79 ± 0.37 a | 6.77 ± 0.82 a | 5.68 ± 0.07 a |
| Ph | 7.81 ± 0.21 a | 5.78 ± 0.81 a | 0.78 ± 0.26 e |
| NC | 0.00 ± 0.00 b | 0.00 ± 0.00 b | 0.00 ± 0.00 f |
| PC | 0.00 ± 0.00 b | 0.00 ± 0.00 b | 0.00 ± 0.00 f |
| p < 0.0001 | p < 0.0001 | p < 0.0001 |
Disclaimer/Publisher’s Note: The statements, opinions and data contained in all publications are solely those of the individual author(s) and contributor(s) and not of MDPI and/or the editor(s). MDPI and/or the editor(s) disclaim responsibility for any injury to people or property resulting from any ideas, methods, instructions or products referred to in the content. |
© 2025 by the authors. Licensee MDPI, Basel, Switzerland. This article is an open access article distributed under the terms and conditions of the Creative Commons Attribution (CC BY) license (https://creativecommons.org/licenses/by/4.0/).
Share and Cite
Elhalag, K.M.; Mazrou, Y.S.A.; Elzaawely, A.A.; Makhlouf, A.H.; Elsaed, S.A.; Maswada, H.F.; Xuan, T.D.; El-Nagar, A. Carrier-Based Application of RsPod1EGY Phage to Effective Control Potato Bacterial Wilt. Horticulturae 2025, 11, 257. https://doi.org/10.3390/horticulturae11030257
Elhalag KM, Mazrou YSA, Elzaawely AA, Makhlouf AH, Elsaed SA, Maswada HF, Xuan TD, El-Nagar A. Carrier-Based Application of RsPod1EGY Phage to Effective Control Potato Bacterial Wilt. Horticulturae. 2025; 11(3):257. https://doi.org/10.3390/horticulturae11030257
Chicago/Turabian StyleElhalag, Kamel M., Yasser S. A. Mazrou, Abdelnaser A. Elzaawely, Abeer H. Makhlouf, Sherine A. Elsaed, Hanafey F. Maswada, Tran Dang Xuan, and Asmaa El-Nagar. 2025. "Carrier-Based Application of RsPod1EGY Phage to Effective Control Potato Bacterial Wilt" Horticulturae 11, no. 3: 257. https://doi.org/10.3390/horticulturae11030257
APA StyleElhalag, K. M., Mazrou, Y. S. A., Elzaawely, A. A., Makhlouf, A. H., Elsaed, S. A., Maswada, H. F., Xuan, T. D., & El-Nagar, A. (2025). Carrier-Based Application of RsPod1EGY Phage to Effective Control Potato Bacterial Wilt. Horticulturae, 11(3), 257. https://doi.org/10.3390/horticulturae11030257









